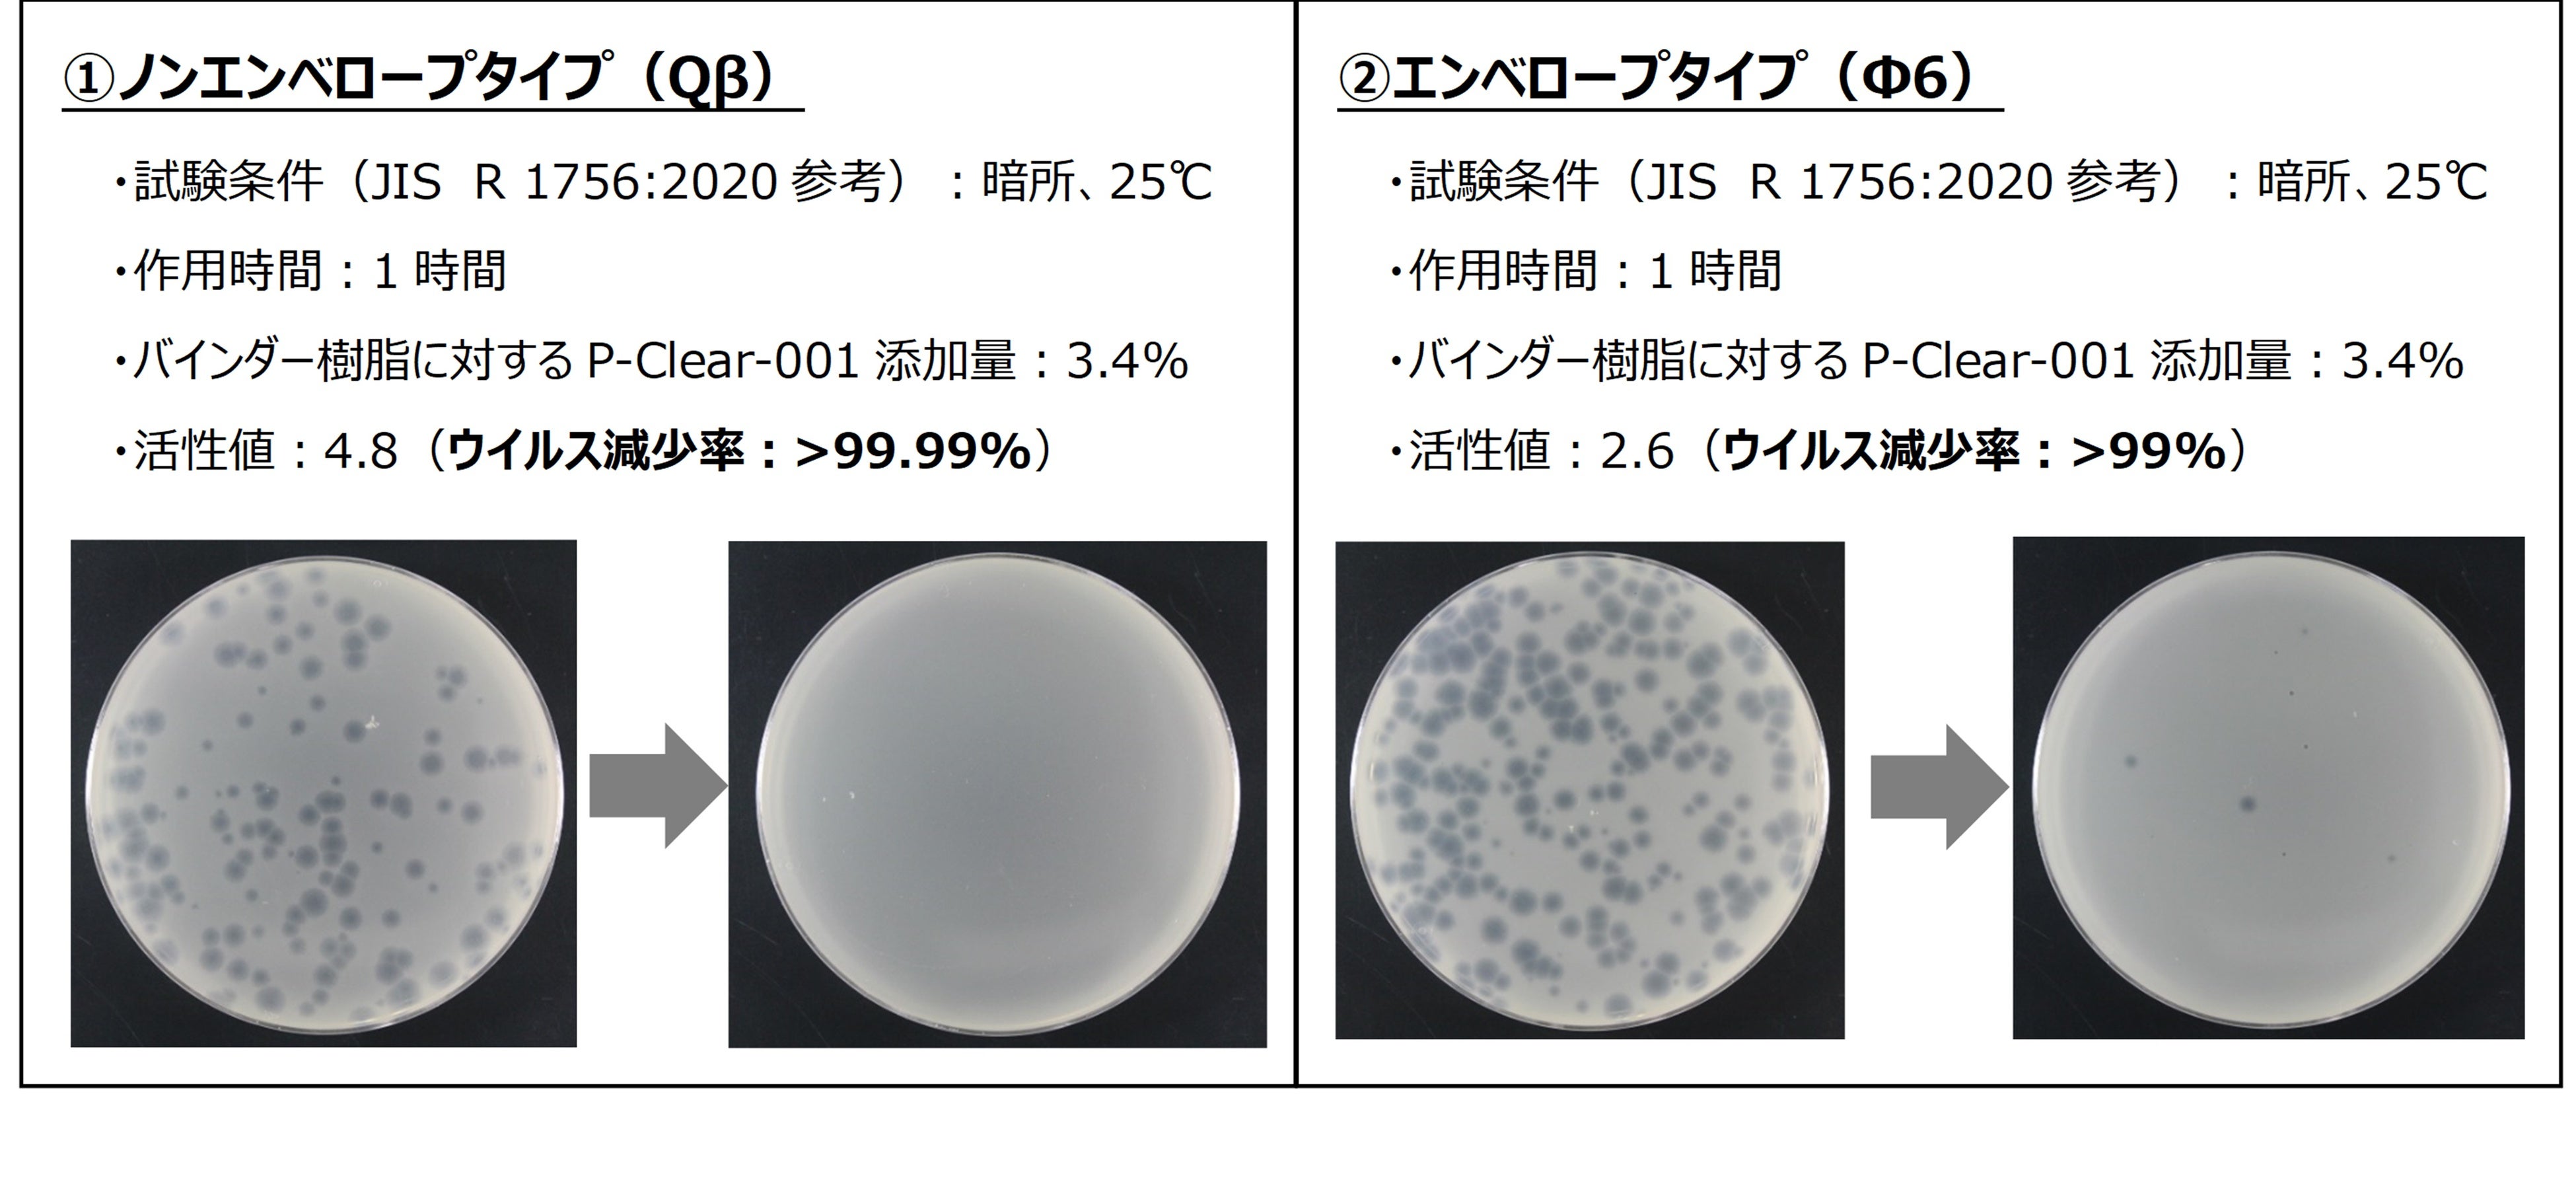
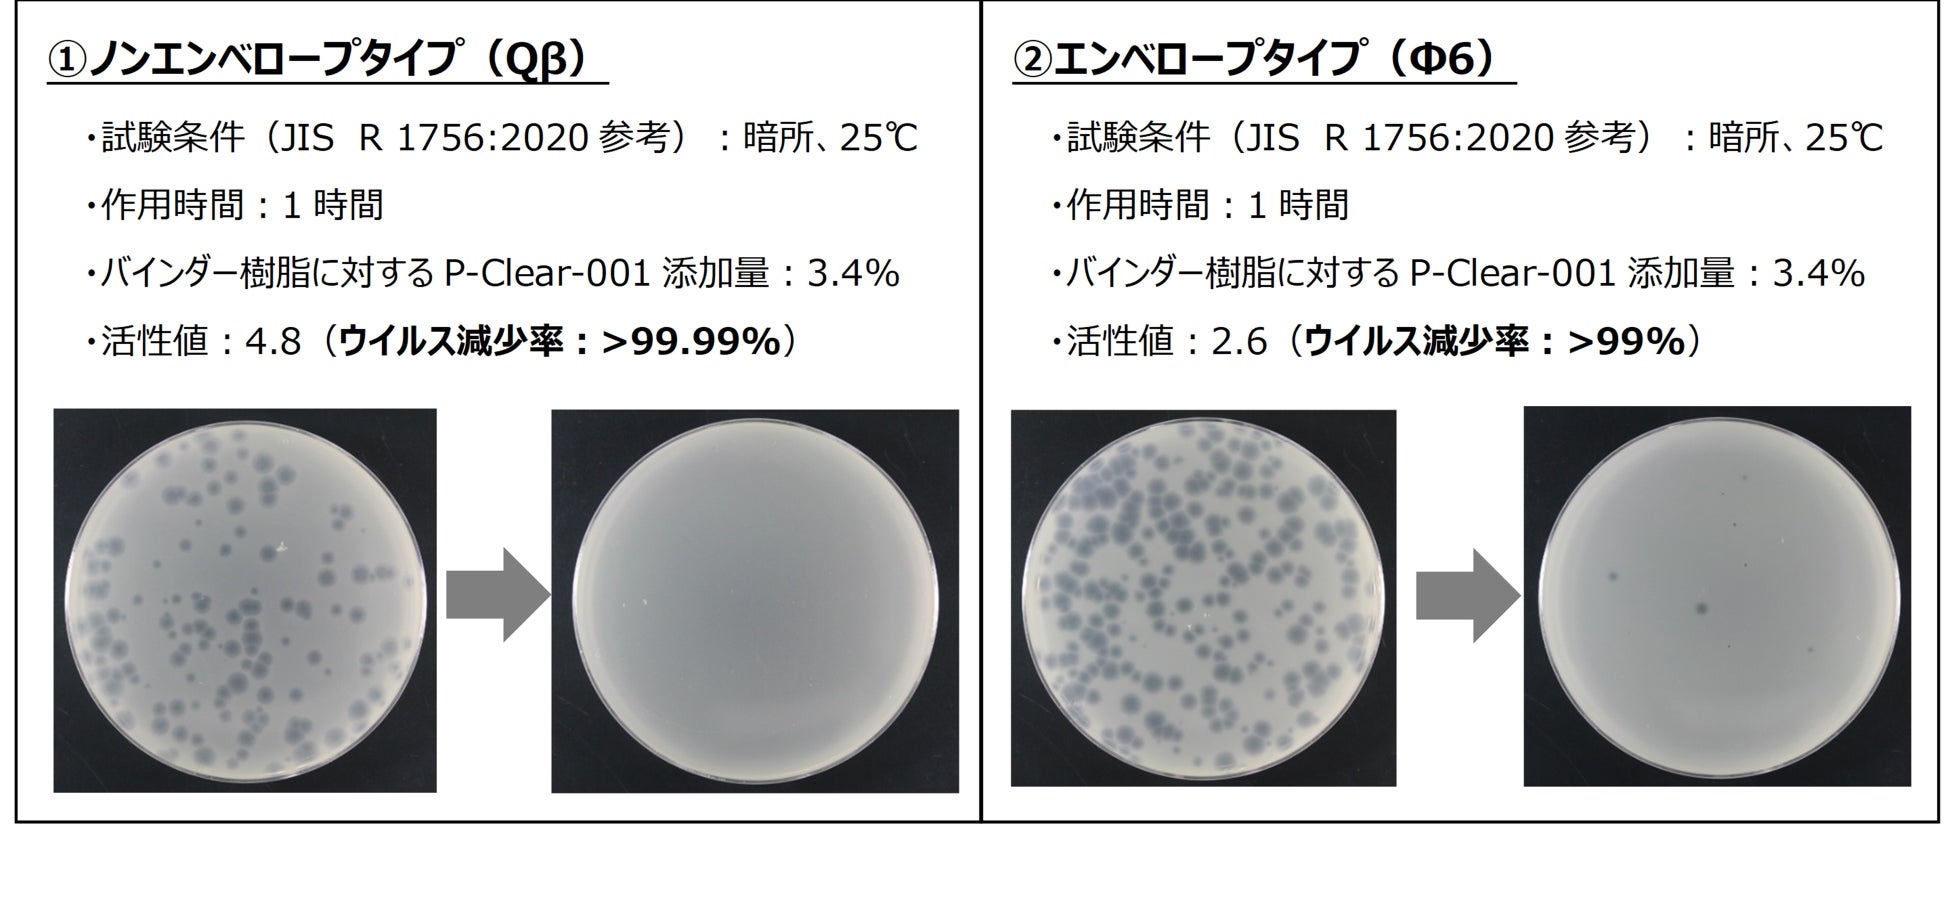

DIC、透明性と即効性に優れた有機系抗ウイルス・抗菌剤「WILMISH ® P-Clear-001」を開発
-新常態に対応した抗ウイルス・抗菌剤のラインアップを拡充し、安全・安心で快適な社会の実現に貢献-
DIC株式会社(本社:東京都中央区、社長執行役員:猪野薫、以下「DIC」)は、このたび透明性と即効性に優れた有機系抗ウイルス・抗菌剤「WILMISH® (ウィルミッシュ) P-Clear-001」を開発しました。本開発品は、高い抗ウイルス・抗菌性を発揮する有機系原料を用いた透明な液体形状の製品です。今後、包装資材、住宅内装材、自動車、電子材料など広範な用途で展開し、2025年に売上高10億円を目指します。
当社が開発した「WILMISH® P-Clear-001」(https://www.dic-global.com/ja/products/wilmish/p-clear/)は、様々な樹脂や塗料材料にも容易に相溶する透明の液体形状であるため、分散剤や分散工程が不要です。さらに、高い透明性を確保できるとともに、即効性もあり短時間でも高い抗ウイルス・抗菌効果を発揮します。本開発品は、特に高い透明性が求められるフィルムや包装材料、透明ニーズや樹脂製品に加えて、外観特性が重要な幅広い製品に対応します。また、外部評価機関で安全性試験を実施しており、一般社団法人抗菌製品技術協議会(SIAA)*1 が定める品質と安全性に関する自主基準を満たしています。
①バインダー樹脂(当社ウレタン樹脂)に本開発品を10%配合し、透明ガラス板に乾燥膜厚60μmで塗工
②バインダー樹脂(当社ウレタン樹脂)に無機系製品を5%配合し、透明ガラス板に乾燥膜厚60μmで塗工
DICグループは、長期経営計画『DIC Vision 2030』において、経営資源を集中する重点事業領域の1つにスマートリビング領域を定めています。当社は本領域において、QOL(Quality of Life)社会に貢献する衛生材料やサステナブル製品の開発・提供を通じて、人々の健康で安全・安心な暮らしの実現と生活空間の快適化に貢献していきます。
*1 SIAAとは、適正で安心できる抗菌加工品の普及を目的とし、抗菌剤・抗菌加工製品のメーカー、試験機関が集まってできた団体。業界だけでなく、消費者代表、専門家及び行政などの幅広い意見を聞きながら、抗菌加工製品に求められる品質や安全性に関するルールを整備し、かつそのルールに適合した製品の安心のシンボルSIAAマーク表示を認めている。
*2 エンベロープタイプとは、外側にエンベロープ(脂質膜)を持つ構造のウイルス。一方、ノンエンベロープタイプは脂質膜を持たず強固なたんぱく質の殻に囲まれた構造のウイルスのこと。
以 上
https://www.dic-global.com/ja/products/wilmish/p-clear/
高い抗ウイルス・抗菌性を発揮する有機系原料を用いた透明性と即効性に優れた製品
■無機系抗ウイルス・抗菌剤「WILMISH® HPSシリーズ」:
https://www.dic-global.com/ja/products/wilmish/hps/
高い抗ウイルス・抗菌性を発揮する“金属化合物”と特殊な“光触媒”から構成される製品
TEL:03-6733-6164 E-MAIL:dic-antivirus-p@ma.dic.co.jp
- 【透明性の評価試験結果】

①バインダー樹脂(当社ウレタン樹脂)に本開発品を10%配合し、透明ガラス板に乾燥膜厚60μmで塗工
②バインダー樹脂(当社ウレタン樹脂)に無機系製品を5%配合し、透明ガラス板に乾燥膜厚60μmで塗工
- 【抗ウイルス・抗菌試験結果】
DICグループは、長期経営計画『DIC Vision 2030』において、経営資源を集中する重点事業領域の1つにスマートリビング領域を定めています。当社は本領域において、QOL(Quality of Life)社会に貢献する衛生材料やサステナブル製品の開発・提供を通じて、人々の健康で安全・安心な暮らしの実現と生活空間の快適化に貢献していきます。
*1 SIAAとは、適正で安心できる抗菌加工品の普及を目的とし、抗菌剤・抗菌加工製品のメーカー、試験機関が集まってできた団体。業界だけでなく、消費者代表、専門家及び行政などの幅広い意見を聞きながら、抗菌加工製品に求められる品質や安全性に関するルールを整備し、かつそのルールに適合した製品の安心のシンボルSIAAマーク表示を認めている。
*2 エンベロープタイプとは、外側にエンベロープ(脂質膜)を持つ構造のウイルス。一方、ノンエンベロープタイプは脂質膜を持たず強固なたんぱく質の殻に囲まれた構造のウイルスのこと。
以 上
- 抗ウイルス・抗菌剤製品ウェブサイト
https://www.dic-global.com/ja/products/wilmish/p-clear/
高い抗ウイルス・抗菌性を発揮する有機系原料を用いた透明性と即効性に優れた製品
■無機系抗ウイルス・抗菌剤「WILMISH® HPSシリーズ」:
https://www.dic-global.com/ja/products/wilmish/hps/
高い抗ウイルス・抗菌性を発揮する“金属化合物”と特殊な“光触媒”から構成される製品
- 製品に関するお問い合わせ
TEL:03-6733-6164 E-MAIL:dic-antivirus-p@ma.dic.co.jp
- DIC株式会社について

このプレスリリースには、メディア関係者向けの情報があります
メディアユーザーログイン既に登録済みの方はこちら
メディアユーザー登録を行うと、企業担当者の連絡先や、イベント・記者会見の情報など様々な特記情報を閲覧できます。※内容はプレスリリースにより異なります。
すべての画像
